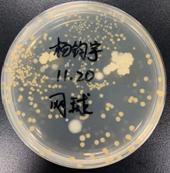

实践教学是培养学生实践能力和创新能力的重要环节,也是提高学生社会职业素养和就业竞争力的重要途径。在教务处和顶通漫画
的共同努力下,今年9月,顶通漫画
开设了文化素质教育课程《生命科学趣味实验》,课程由顶通漫画
何晓晓、郭新红、孟祥贤、郭秋平、卓睿、邱烨、黄明敏、唐松青等老师主讲。
为了保证教学效果,让每个学生都实实在在地动手开展每一个实验,这次我们开了两个班级,每班30人,两个班都选满共60人,选课学生来自电气与信息工程学院、土木工程学院、外国语学院、法学院等十四个学院。课程共32个学时,内容包括显微镜的使用、家鸡的外形和内部解剖、ABO血型鉴定及血涂片的制作与血细胞显微观察、人体九大系统自我认知、叶片的构造及“叶脉书签”的制作、常见植物的认知、质粒DNA的提取、环境微生物的培养检测、实验测试等教学内容。


图:师生合影
该课程为顶通漫画
首次组织开设的实验类校级通识选修课,得到了学生的好评。通过实验课不仅能激发学生的学习兴趣,还能培养学生的观察能力、思维能力和动手操作能力。该课程对培养学生的生命科学素养具有重要意义,也提高了实验室的有效开放,对提高实验仪器设备使用率和调动实验室工作人员的积极性也起到了很好的推动作用。

图:实验结果展示(部分)


图:学生心得体会(部分)
2019年12月17日文|李永亮图|李永亮
